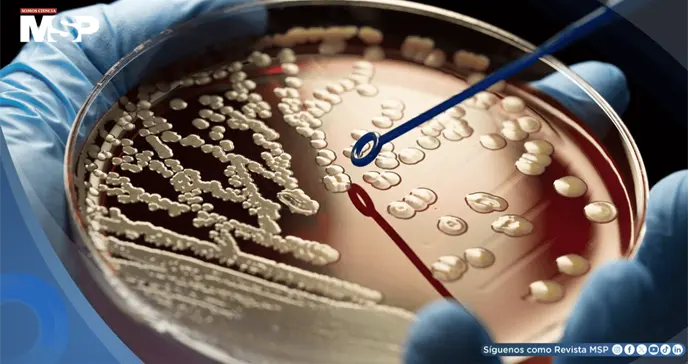
Alertan sobre el aumento de bacterias resistentes a antibióticos en República Dominicana

El organismo advierte que bacterias como E. coli, Klebsiella y Staphylococcus aureus muestran resistencia a múltiples fármacos, comprometiendo la capacidad del sistema de salud para tratar infecciones comunes.
La Sociedad Dominicana de Infectología (SDI) mantiene bajo vigilancia el incremento sostenido de la resistencia a los antimicrobianos (RAM) en la República Dominicana, una amenaza que crece de manera preocupante según el Boletín Epidemiológico más reciente de la Dirección General de Epidemiología.
El informe reportó un aumento significativo de bacterias resistentes en los últimos años, con especial predominio de Escherichia coli, Klebsiella spp. y Staphylococcus aureus, incluyendo cepas resistentes a múltiples fármacos.
Esta situación compromete seriamente la capacidad del sistema de salud para tratar infecciones comunes y complejiza la atención de pacientes hospitalizados.
La SDI señaló que este comportamiento bacteriano afecta especialmente a pacientes sometidos a cirugías, cuidados intensivos, trasplantes, tratamientos oncológicos o terapias inmunosupresoras, quienes dependen de antibióticos efectivos para prevenir y tratar infecciones.
La resistencia a los antimicrobianos es reconocida por la Organización Mundial de la Salud (OMS) como una de las diez amenazas más importantes para la salud pública global, y su avance en la región demanda acciones integradas, inmediatas y sostenidas.
En consecuencia, la SDI hizo un llamado a redoblar los esfuerzos nacionales para fortalecer la vigilancia epidemiológica, ampliando y modernizando la red de microbiología en hospitales públicos y privados, y reportando los datos de resistencia de manera oportuna para permitir una pronta respuesta de los organismos sanitarios.
Además, la sociedad científica recomendó implementar Programas de Optimización de Antimicrobianos (PROA), que incorporen equipos multidisciplinarios compuestos por especialistas en infectología, farmacia clínica, microbiología y epidemiología hospitalaria.
También instó a promover la prescripción responsable de antibióticos y mantener bajo vigilancia los antimicrobianos de uso restringido.
Entre las medidas prioritarias, la SDI destacó la necesidad de reforzar el cumplimiento del uso de antibióticos bajo receta médica y combatir la automedicación y venta informal de estos fármacos, prácticas que aceleran el desarrollo de resistencia bacteriana.
Asimismo, sugirió fortalecer las medidas de higiene de manos para prevenir infecciones y aumentar la cobertura de vacunación para enfermedades como la influenza, el neumococo, el Covid-19 y la hepatitis B, con el objetivo de reducir la necesidad de antibióticos.
Un informe publicado en octubre pasado por la OMS, divulgado por la agencia Europa Press, advirtió sobre el aumento global de la resistencia a los antibióticos esenciales.
Entre 2018 y 2023, la resistencia creció en más del 40 por ciento de las combinaciones de patógenos y antibióticos supervisados.
El estudio reveló que en 2023, una de cada seis infecciones bacterianas era resistente a los tratamientos con antibióticos. El informe mundial estimó que 22 antibióticos utilizados para tratar infecciones urinarias y gastrointestinales muestran resistencia.
El documento de la OMS abarcó ocho patógenos bacterianos comunes: Acinetobacter spp., Escherichia coli, Klebsiella pneumoniae, Neisseria gonorrhoeae, Salmonella spp. no tifoidea, Shigella spp., Staphylococcus aureus y Streptococcus pneumoniae, cada uno relacionado con diversas infecciones.
La organización internacional identificó que las bacterias gramnegativas resistentes a los medicamentos son cada vez más peligrosas. Entre ellas, E. coli y K. pneumoniae fueron catalogadas como las principales bacterias de este tipo resistentes a los fármacos.
En las regiones del Sudeste Asiático y el Mediterráneo Oriental, la OMS estima que una de cada tres infecciones muestra resistencia a los antibióticos, evidenciando la magnitud global de esta crisis sanitaria.